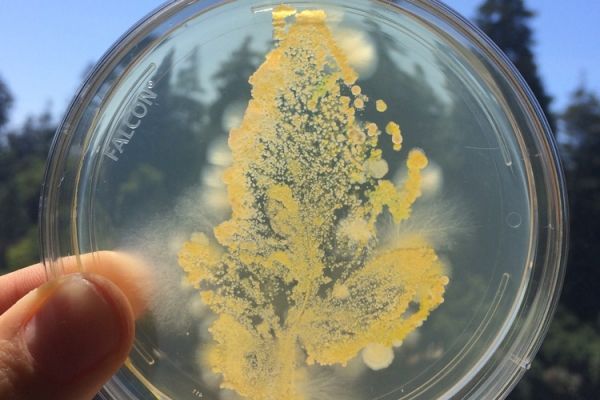

Is there even such a thing as a healthy plant microbiome in today’s agricultural fields, with acres of identical plants assaulted by pesticides and herbicides and hyped up on fertilizer?
A new study by University of California, Berkeley, microbial ecologists used experimental evolution to help identify the core microbiome of commercial tomatoes. They selected for those microbial taxa that best survived on the plants and then showed that these “domesticated” microbial communities are able to effectively fend off random microbes that land on the plants. In other words, these selected communities look like a stable, healthy plant microbiome, akin to what a robust tomato plant might pass to its offspring.
The results are good news for growers who hope that manipulating the plant microbiome, perhaps with probiotics, will make for healthier fields that need less fertilizer and less or no pesticides to produce good yields.
Continue reading at University of California Berkeley
Image via University of California Berkeley